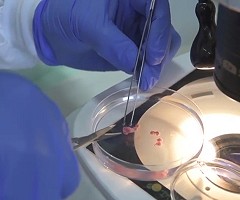
Ex utero Mouse Embryogenesis from Pre-Gastrulation to Late Organogenesis - Jacob Hanna Lab (YouTube)

2021
-
-
¡Los nuevos MiniCursos en línea de JAX en español!
30 March 2021 -
La relación entre la obesidad y la depresión
30 March 2021 -
-
-
-
Publicado el primer Atlas de radiología del ratón
27 March 2021 -
-
-